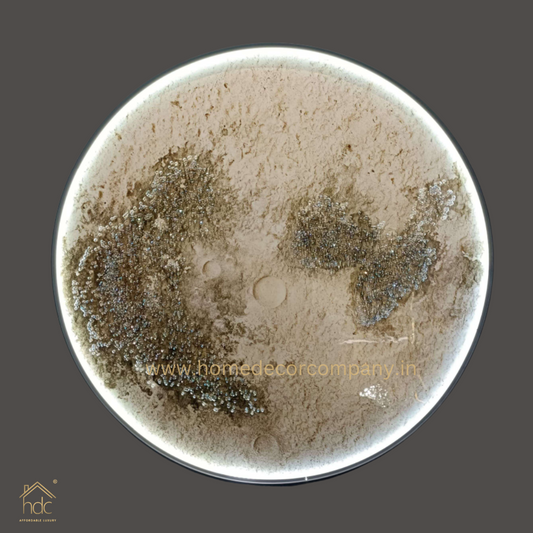

-
HDC Modern Home Decoration 900mm LED Planet Moon Wall Night Light Bedside Ceiling Light Wall Lamp With Remote
Vendor:HDC.INRegular price Rs. 11,799.00Regular priceUnit price perRs. 21,999.00Sale price Rs. 11,799.00Sold out -
HDC Modern Home Decoration 900mm LED Planet Earth Wall Night Light Bedside Ceiling Light Wall Lamp With Remote
Vendor:HDC.INRegular price Rs. 11,799.00Regular priceUnit price perRs. 21,999.00Sale price Rs. 11,799.00Sale -
HDC Modern Home Decoration 900mm LED Planet Wall Night Light Bedside Ceiling Light Wall Lamp With Remote
Vendor:HDC.INRegular price Rs. 11,799.00Regular priceUnit price perRs. 21,999.00Sale price Rs. 11,799.00Sale -
HDC Modern Home Decoration 900mm LED Planet Venus Wall Night Light Bedside Ceiling Light Wall Lamp With Remote
Vendor:HDC.INRegular price Rs. 11,799.00Regular priceUnit price perRs. 21,999.00Sale price Rs. 11,799.00Sale -
HDC Modern Home Decoration LED Planet Moon Wall Night Light Bedside Ceiling Light Wall Lamp for Bedroom Living Room
Vendor:HDC.INRegular price From Rs. 2,499.00Regular priceUnit price perRs. 5,999.00Sale price From Rs. 2,499.00Sale -
HDC Modern Home Decoration LED Planet Earth Wall Night Light Bedside Ceiling Light Wall Lamp for Bedroom Living Room
Vendor:HDC.INRegular price From Rs. 2,499.00Regular priceUnit price perRs. 5,999.00Sale price From Rs. 2,499.00Sale -
Hdc Modern Simple Moon Bedroom Bedside Wall Lamp- Tricolor
Vendor:HDC.INRegular price Rs. 2,999.00Regular priceUnit price perRs. 5,999.00Sale price Rs. 2,999.00Sold out -
Hdc 300/400mm Modern Simple Moon Bedroom Bedside Wall Lamp
Vendor:HDC.INRegular price From Rs. 3,799.00Regular priceUnit price perRs. 6,999.00Sale price From Rs. 3,799.00Sale -
Hdc 300/400mm Modern Simple Moon Bedroom Bedside Wall Lamp
Vendor:HDC.INRegular price From Rs. 3,799.00Regular priceUnit price perRs. 6,999.00Sale price From Rs. 3,799.00Sale -
Hdc 600mm Modern Simple Moon Bedroom Bedside Wall Lamp
Vendor:HDC.INRegular price Rs. 9,999.00Regular priceUnit price perRs. 17,999.00Sale price Rs. 9,999.00Sold out -
Hdc 800mm Modern Beautyful Round Moon Structure LED Crystal Painting for Home Decor Of Living Room Three-Dimensional LED Light Wall Art (Dia-32 IN)
Vendor:HDC.INRegular price Rs. 12,299.00Regular priceUnit price perRs. 21,299.00Sale price Rs. 12,299.00Sale -
HDC Led Moon Wall Light Outdoor Indoor Light - Tricolor
Vendor:HDC.INRegular price From Rs. 2,799.00Regular priceUnit price perRs. 7,999.00Sale price From Rs. 2,799.00Sale
Let customers speak for us
Why Choose HDC Lights?
At Home Decor Company, we offer more than just lighting — we deliver affordable luxury that transforms your spaces into elegant experiences. From grand double-height chandeliers to minimalist pendant lights, every item in our collection is handpicked for quality, style, and uniqueness.